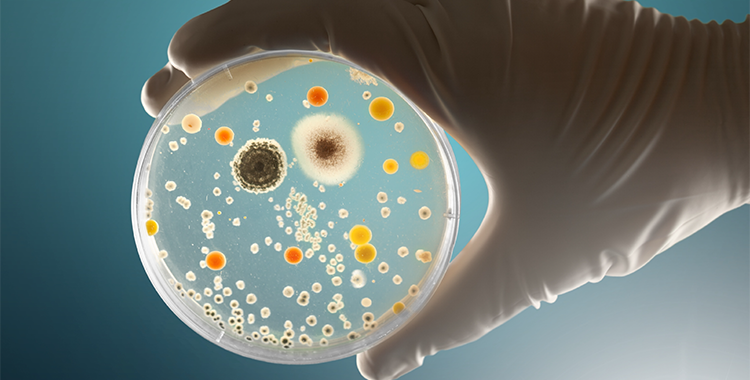

Horario y duración
Microorganismos de importancia en alimentos y formas de prevención
El conocimiento de los microorganismos que afectan los alimentos es esencial para prevenir contaminaciones, proteger la salud del consumidor y garantizar la inocuidad en los procesos de producción.
Este curso te brinda las herramientas necesarias para identificar los principales microorganismos patógenos y alterantes, comprender sus condiciones de crecimiento y aplicar medidas efectivas de prevención y control en la industria alimentaria.
Temas principales:
✅ Microorganismos patógenos y su impacto en la salud pública
✅ Factores que favorecen el crecimiento microbiano
✅ Buenas prácticas de higiene y control en el proceso productivo
✅ Estrategias de prevención y verificación de la inocuidad
Dirigido a:
✔️ Encargados de inocuidad y calidad
✔️ Personal de plantas de alimentos y bebidas
✔️ Consultores, auditores y supervisores del sector alimentario